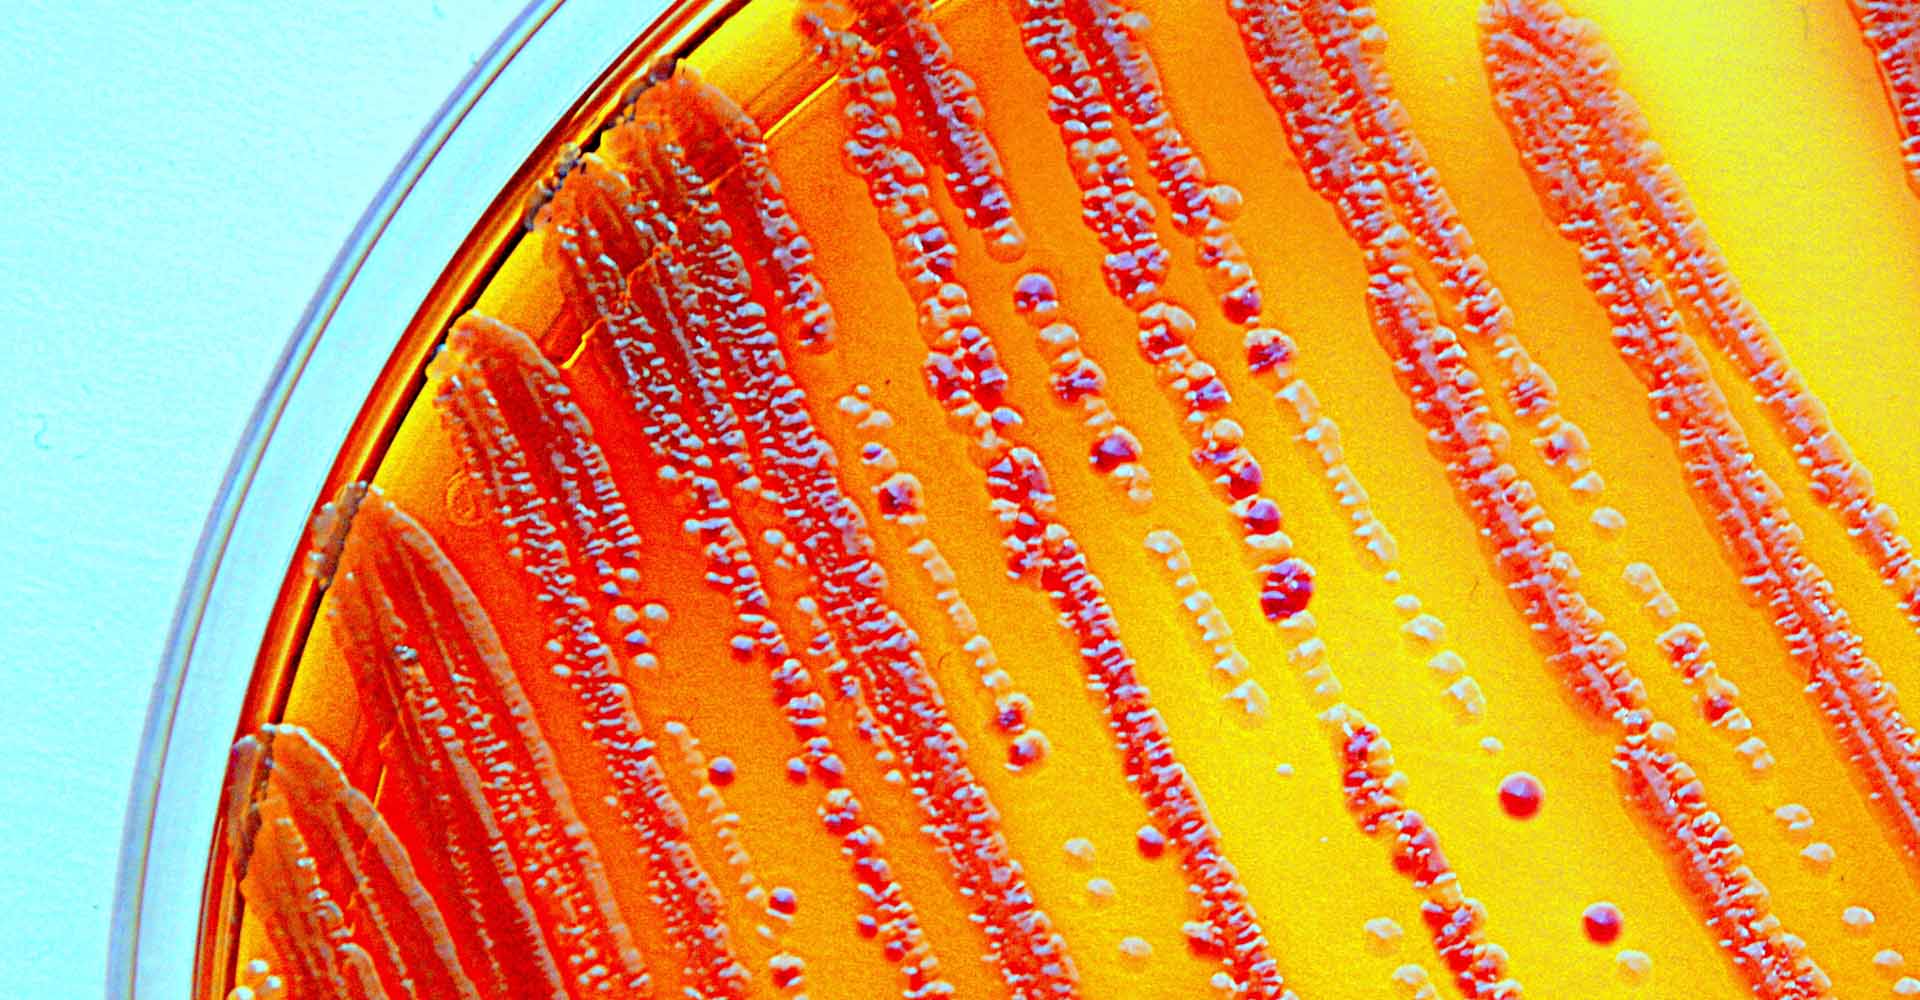

Бактерии семейства enterobacteriaceae
Прана это что такое простыми словами
Дамский парикмахерская
Ф гизо что открыл
Мтс усть кут
Вяткина киров
Ученики шутят
Им можно а нам нельзя
Боты которые пробивают данные
Биологические свойства крахмала
Какой частью речи является слово севере
Джек ф 5
Липки сверху
Past continuous interrupted action
Бактерии семейства enterobacteriaceae 116 фото